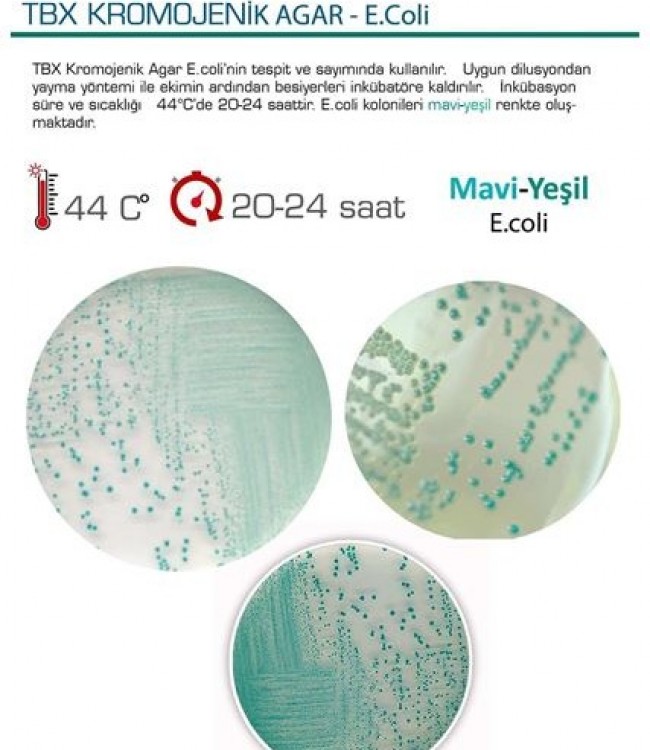
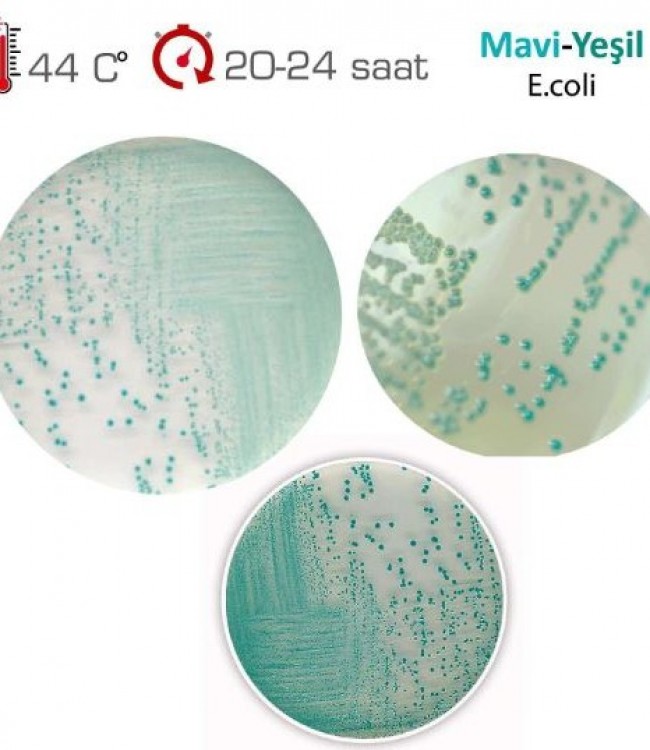
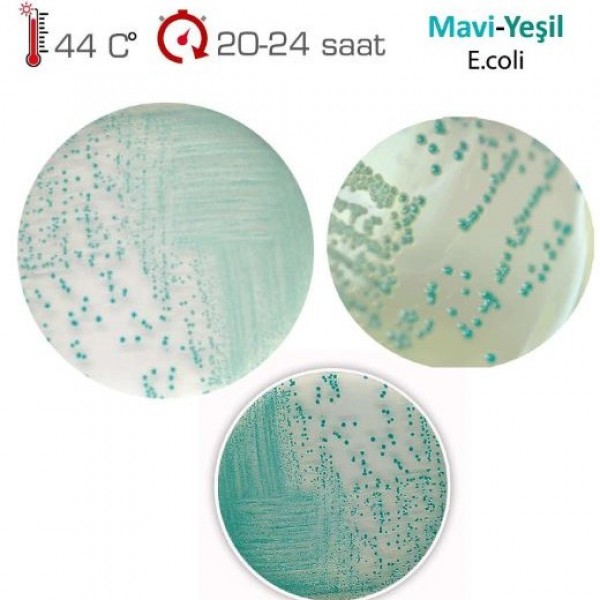

TBX Kromojenik Agar - E. Coli
TBX KROMOJENİK AGAR - E.Coli
TBX Kromojenik Agar E.coli’nin tespit ve sayımında kullanılır.
Uygun dilusyondan yayma yöntemi ile ekimin ardından besiyerleri inkübatöre kaldırılır.
İnkübasyon süre ve sıcaklığı 44 C’de 20-24 saattir.
E.coli kolonileri mavi-yeşil renkte oluşmaktadır.